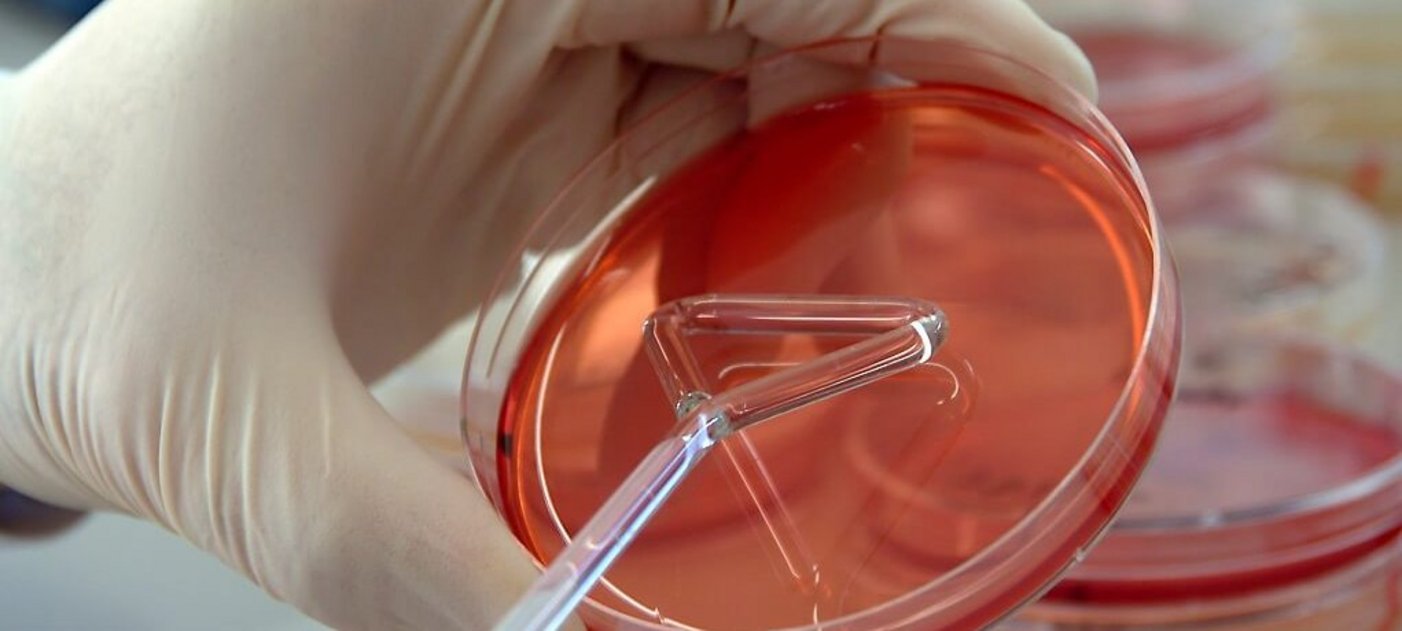

Untersuchung von Milchproben
Mastitisdiagnostik
Im Zuge der klinischen Untersuchung der Patienten werden bei allen laktierenden Kühen aseptische Milchproben entnommen und im klinikeigenen Milchlabor bakteriologisch untersucht. Durch dieses – für die Tierbesitzer:innen kostenlose – Service werden vorhandene Keime identifiziert und unter Verwendung eines Antibiogrammes mit dem bestgeeignetem Antibiotikum therapiert.
Blutuntersuchung
Die morphologische und klinisch-chemische Untersuchung des Blutes inklusive der Erhebung spezieller Parameter wie zum Beispiel für Lebererkrankungen-spezifische Enzyme oder der Mineralstoffe wird in Kooperation mit der Plattform Labordiagnostik der Vetmeduni durchgeführt. Mittels der Blutuntersuchung können klinisch erhobene Verdachtsdiagnosen (wie zum Beispiel Lebererkrankungen oder Mineralstoffwechselstörungen) bestätigt werden.
Harnuntersuchung
Mittels der physikalischen und chemischen Harnuntersuchung können Erkrankungen des gesamten Harntraktes (Niere, Harnleiter, Blase, Harnröhre) erkannt werden. So kann beispielsweise die klinische Verdachtsdiagnose „Ketose" durch den Nachweis von Ketonkörpern im Harn bestätigt werden. Mittels bakteriologischer Untersuchung des Harns lassen sich krankmachende Keime, die zum Beispiel Blasenentzündung auslösen können, identifizieren. In der Folge wird mit Hilfe eines Antibiogrammes das bestgeeignetste Antibiotikum bestimmt.
Kotuntersuchung auf Endoparasiten
Mittels parasitologischer Kotuntersuchung (in interner Kooperation mit Einrichtugen der Vetmeduni) können Endoparasiten wie zum Beispiel Lungenwürmer, Band- und Rundwürmer, Leberegel etc. nachgewiesen und in der Folge gezielt bekämpft werden.